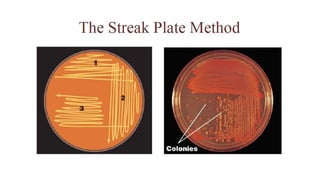
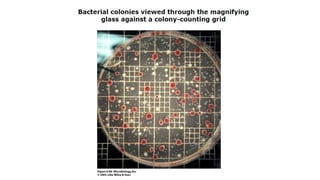
3. Microbial nutrition and growth (Microbiology)
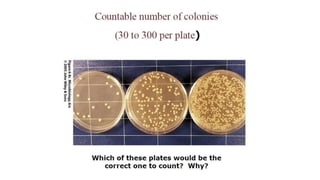
3. Microbial nutrition and growth (Microbiology)

Microorganisms require nutrients like carbon, hydrogen, nitrogen, and oxygen to obtain energy and synthesize cellular components through biosynthesis. They use these nutrients for growth. When microorganisms live in or on a host to obtain nutrients, they can cause disease by interfering with the host's nutrition, metabolism, and homeostasis. The key physical factors required for bacterial growth are temperature, pH, oxygen, hydrostatic pressure, osmotic pressure, and the key chemical/nutritional factors are carbon, nitrogen, sulfur, phosphorus, trace elements, and organic growth factors.